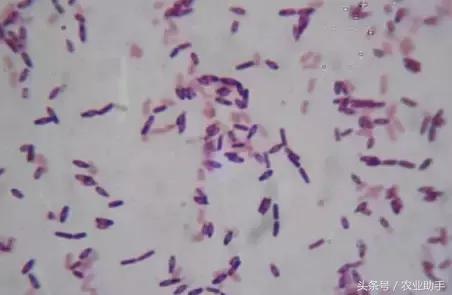
枯草芽孢杆菌能浇花吗,枯草芽孢杆菌生产方法

枯草芽孢杆菌 图片来源:流浪天涯博客枯草芽孢杆菌在自然界中广泛存在,不仅活跃于土壤、植物根际、体表等外界环境中,同时还是植物体内常见的内生细菌,对人畜无毒无害,不污染环境,具有显著的抗菌活性和极强的抗逆能力。

枯草芽孢杆菌生长快、营养简单,能产生耐热、抗逆的芽孢,可以制成各种剂型;与化学农药混用而不失活,而且批量生产工艺简单,成本也较低,施用方便,储存期长。实乃种植生产,必备良药! 枯草芽孢杆菌的功效 枯草芽孢杆菌对植物的作用主要体现在以下几个方面: 营养和空间位点的竞争

土壤中的微生物 图片来源:http://www.isa.ac.cn枯草芽孢杆菌的竞争作用主要包括营养竞争和空间位点竞争。可以在植物根际、 体表或体内及土壤中快速、大量繁衍和定殖,有效地排斥、阻止和干扰植物病原微生物在植物上的定殖与侵染,从而达到抑菌和防病的效果。 产生抑菌物质枯草芽孢杆菌菌落 图片来源:小木虫枯草芽孢杆菌在生长过程中能产生多种具有抑菌、溶菌作用的物质,如枯草菌素、有机酸、抗菌蛋白等等,这些物质可以抑制病原菌的生长和繁殖,甚至破坏细菌结构,杀死病原菌。因此,枯草芽孢杆菌对于重茬病、根腐病、灰霉病等疾病防治效果很好。 增强免疫促进生长

图片来源:http://www.daimg.com
枯草芽孢杆菌可以分泌活性物质,激活植物防御系统,增强作物的免疫力与抗病性,减轻或消除病原菌对植株的危害。还可促进多种植物种子、幼苗和根系的生长发育,增强了植物的抗病性, 从而间接地减少病害发生。如增加吲哚乙酸等生长素的形成,刺激作物根系发育,增强光合作用。同时将土壤中难吸收的物质转化为易于作物吸收的物质,促进作物对营养物质的吸收利用,提高肥料利用率。 诱导植物产生抗性水稻纹枯病
枯草芽孢杆菌不但能直接抑制植物病原菌,而且能通过诱发植物自身的抗病潜能从而增强植物的抗病性。如水稻纹枯病生防菌枯草芽孢杆菌,能诱导水稻叶鞘细胞抗病相关的酶(POD、PPO和SOD)活性增强,达到抗病效果。改善土壤结构

图片来源:http://www.taopic.com
枯草芽孢杆菌在土壤中形成益生菌环境,促进团粒结构形成,提高土壤保肥保水能力,增加土壤疏松度,促进根系生长。具体表现在,加速养料矿质化,将养分由无效态和缓效态变为有效态和速效态。同时,加速养料腐殖化,分泌植酸酶,降解土壤中大部分的植酸盐;产生生长素,刺激作物生长,提高种子的成活率和出苗率。
使用注意事项

枯草芽孢杆菌主要用于调节土壤、喷雾,也可灌根、拌种及种子包衣等。喷雾时要注意以下几点:
● 由于使用量少,为减少浪费,务必采用二次稀释法配置。
● 早上10点前或下午4点后施药,避免阳光直射,杀死芽孢。尤其是4点后用药,夜间潮湿的环境更有利于芽孢 萌发。● 不能与铜制剂、链霉素等杀菌剂及碱性农药混用。
● 病害初期或发病前施药效果最佳,施药时注意使药液均匀喷至作物各部位。
枯草芽孢杆菌的优劣判别

列夫·托尔斯泰曾说过:幸福的人都是相似的,不幸的人各有各的不幸。所以优质的枯草芽孢杆菌我们就不多做讨论了,来看看这些假冒伪劣的通常都是些什么套路。
①价位便宜,一般用一些激素或肥料冒充,即完全当成肥料来卖。
②效果非常快,打上当天见效。
③用后易引起作物早衰,因为激素的作用品质产量反而降低。 总之,真正的枯草芽孢杆菌是一种生物制剂,对作物、对土壤都有很好的生长调节作用,基本是多功能的,不可能只针对一点起作用,最重要的是它的使用效果是累加的,是单纯的肥料或激素达不到的。
本文由农业助手团队编写整理,转载请务必注明来源农业助手,转载时请勿修改文章内容,修改必究!
参考资料
《枯草芽孢杆菌对植物病害生物防治的作用机理》
赵新林《判断枯草芽孢杆菌优劣及实验方法》 上海一新